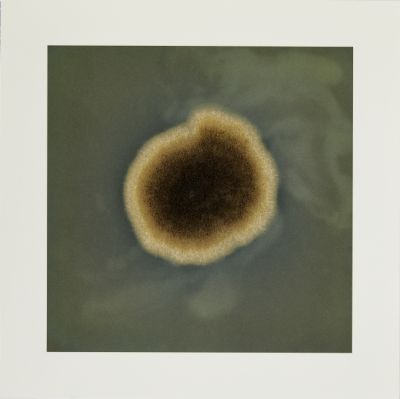

0 avis
Fungi 1 / Dove Allouche
Estampe
Du dessin à la photographie, le travail de Dove Allouche ne se situe jamais complètement dans l’un ou l’autre. Il s’intéresse plutôt aux conditions d’apparition des images où le medium n’a de sens que dans sa relation mutuelle avec le sujet. Ses projets artistiques prennent souvent source dans le réel ou la manifestation de phénomènes naturels. La plupart de ses images mettent en tension une énergie quasi organique de la matière et l’idée d’une temporalité indéfiniment étirée qui lui permet de projeter dans le présent quelque chose qu’il recherche dans le passé. Avec la série « Fungi », Dove Allouche recentre son travail sur le vivant et utilise ainsi des espèces de spores dangereuses pour l'homme. Il recueille des échantillons auprès de différents musées et les met en culture afin d'observer leur croissance, en cercles qui s'élargissent. À un moment donné de leur développement, il les photographie, puis les reproduit selon différents procédés d'impression.